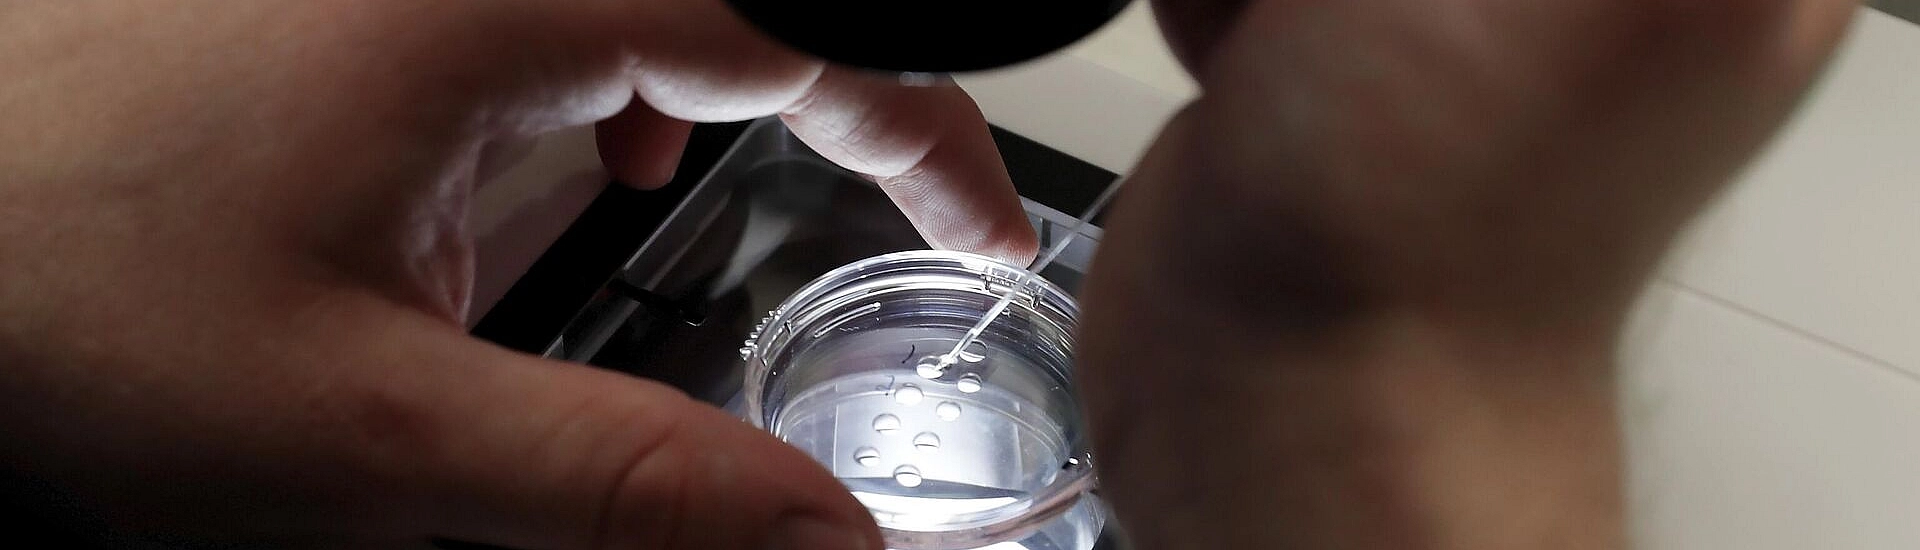
В Белоруссии предложили расширить программу ЭКО до двух бесплатных попыток

Соответствующий проект указа уже представлен президенту Александру Лукашенко, а детали озвучила заместитель премьер-министра Наталья Петкевич.
Документ предусматривает, что воспользоваться двумя бесплатными попытками ЭКО смогут не только женщины, состоящие в браке, но и одинокие. По словам Натальи Петкевич, Александр Лукашенко поддерживает идею расширения доступа к процедуре и считает важным дать женщинам такую возможность.
Она подчеркнула, что даже если мера не приведёт к резкому росту рождаемости, каждый ребёнок остаётся значимым для страны и общества.
Также Наталья Петкевич сообщила, что глава государства поручил дополнительно обсудить проект с Белорусским союзом женщин, чтобы учесть позицию не только специалистов в медицине, но и общественных объединений. Кроме того, Александр Лукашенко указал на необходимость изучения лучших международных практик проведения ЭКО на всех этапах.
По словам вице-премьера, государство готово обеспечить все необходимые условия для развития этой сферы, включая возможное дополнительное финансирование, чтобы национальная система соответствовала современным мировым стандартам.
В Беларуси программы ЭКО за счёт бюджета действуют с 2012 года, однако сейчас предусматривается только одна бесплатная попытка. Александр Лукашенко ранее отмечал, что подход к таким процедурам следует сделать более гибким и доступным.